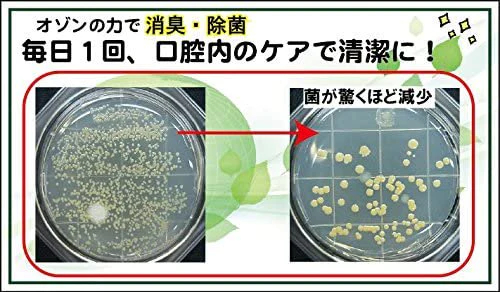

オゾニールD 口臭・口腔内お悩みケア
特長
【特徴】
●主成分はオゾン化オリーブ油です。
●オゾンの消臭・除菌力で、口腔内の清潔を保ち、歯石や口臭を予防します。
仕様
【仕様】
【原材料】
●オゾン化オリーブ油、オゾン化ヒマワリ種子油
※使用の際は、商品に記載している詳細情報をご確認ください。
詳細説明

【特徴】
●主成分はオゾン化オリーブ油です。
●オゾンの消臭・除菌力で、口腔内の清潔を保ち、歯石や口臭を予防します。
【仕様】
【原材料】
●オゾン化オリーブ油、オゾン化ヒマワリ種子油
※使用の際は、商品に記載している詳細情報をご確認ください。